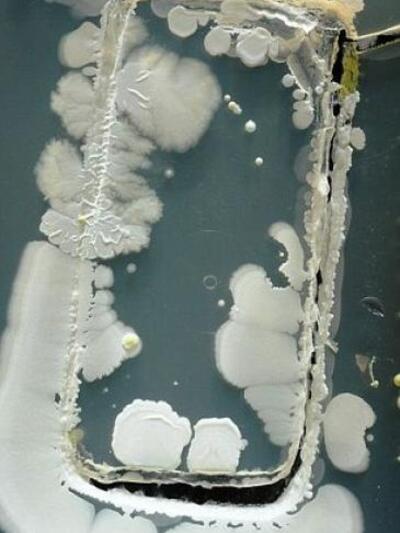
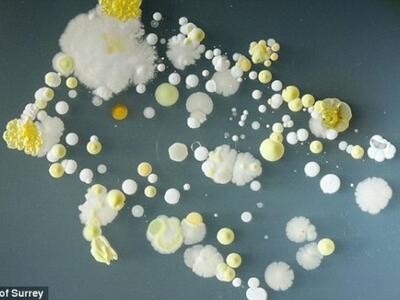

Δείτε ΦΩΤΟ
Άμα σπάνια αποχωρίζεστε το κινητό σας, τότε καλά θα κάνετε να δείτε τις παρακάτω ανησυχητικές «φωτογραφίες μικροβίων» πάνω στο κινητό.
Τα κινητά τηλέφωνα, λόγω της συνεχόμενης χρήσης και της λάθος απολύμανσης των χεριών, έχουν πάνω τους εκατομμύρια βακτήρια. Βέβαια, στις περισσότερες περιπτώσεις, τα βακτήρια που «κατοικούν» πάνω στο κινητό, δεν είναι επικίνδυνα.

Αλλά υπάρχουν και περιπτώσεις όπου τα βακτήρια, μπορεί να προκαλέσουν από τροφική δηλητηρίαση, δερματικές μολύνσεις μέχρι και σηψαιμία.

Το επίπεδο της βρωμιάς πάνω σε ένα κινητό τηλέφωνο, μπορεί να συσχετιστεί με εκείνο πάνω στα άπλυτα πιάτα, που έχουν μείνει στον νεροχύτη για τρεις μέρες. Σε μερικές περιπτώσεις μάλιστα, ύστερα από μελέτη του πανεπιστημίου του Surrey, βρέθηκαν ορισμένα είδη του βακτηρίου του σταφυλόκοκκου, πολύ επικίνδυνα για τον οργανισμό, που μπορεί να προκαλέσουν ακόμα και πνευμονία και σηψαιμία. Μερικές φορές μάλιστα, πρόσφατες έρευνες έδειξαν ότι, το κινητό μπορεί να «κουβαλά» περισσότερα μικρόβια και από μία τουαλέτα.

Πηγή: iefimerida.gr
Ακολουθήστε το thebest.gr στο Google News και μάθετε πρώτοι όλες τις ειδήσεις
Δείτε όλες τις τελευταίες Ειδήσεις από την Ελλάδα και τον Κόσμο, τη στιγμή που συμβαίνουν, στο thebest.gr











